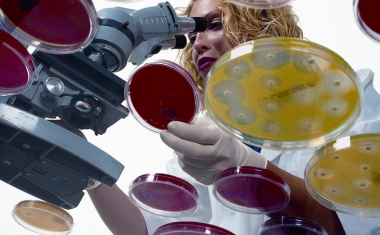
Photo

Warum sicheres Chargenmanagement für die Prozessindustrie ein Muss ist
Höchste Sicherheit und makellose Qualität erreicht die Prozessindustrie mit zuverlässigem Chargenmanagement. Diese Tipps machen Sie zum Chargen-Profi!

Höchste Sicherheit und makellose Qualität erreicht die Prozessindustrie mit zuverlässigem Chargenmanagement. Diese Tipps machen Sie zum Chargen-Profi!

Chemiedistributoren spielen eine zentrale Rolle in der Versorgung der produzierenden Industrie mit Rohstoffen. Besonders in der stark regulierten Pharmaindustrie reicht ihre Rolle weit über die reine rechtliche Funktion des Ein- und Verkaufs von Rohstoffen hinaus.

Cannabis ist eine seit Jahrtausenden kultivierte Nutzpflanze, die zahlreiche pharmakologisch wirksame Substanzen enthält. In den letzten Jahren hat Cannabis in der Medizin zunehmend an Bedeutung gewonnen, weshalb effiziente Verfahren zur Extraktion und Isolation der Wirkstoffe aus der Cannabis-Pflanze immer wichtiger werden.

Kostenloses englischsprachiges eBook über moderne Granuliertechniken für die Fertigung fester, oral verabreichter Pharmaka (OSD).

Die Chemiebranche steht vor einer Reihe von Herausforderungen. Die Coronakrise hat die Branche hart getroffen, und der Ausbruch des Ukraine-Kriegs hat zu hohen Energiepreisen und Versorgungsengpässen bei Rohstoffen geführt. Hinzu kommt die dringend notwendige Transformation zur Klimaneutralität und Kreislaufwirtschaft. Aufgrund der demografischen Entwicklung mangelt es zunehmend an gut ausgebildeten Fachkräften. Hohe regulatorische Vorgaben und weiter steigende Anforderungen erfordern immense Ressourcen.

Es gibt in der Chemieindustrie nicht viele Unternehmen, die auf eine 120-jährige Geschichte zurückblicken können und immer noch unter dem Gründungsnamen firmieren.

Die optimale Lösung zur Temperierung von technischen Anwendungen

Wer in einem Labor arbeitet, muss sich mit den Regeln und Vorkehrungen für sicheres Arbeiten vertraut machen. Im Laboralltag ist es oft nicht einfach, den Überblick über alle Richtlinien und die vielen Aspekte, die für sicheres Arbeiten wichtig sind, zu behalten.

Plastik ist überall: Forscher haben es sowohl auf dem Mount Everest als auch im Marianengraben nachgewiesen. Besonders alarmierend war die kürzlich veröffentlichte Studie, die Mikroplastik sogar im menschlichen Blut fand.

Infraserv Höchst wird 25 Jahre alt: Im Jahr 1997 ist die Betreibergesellschaft des Industrieparks Höchst an den Start gegangen. Was in Folge der Umstrukturierung der ehemaligen Hoechst AG im Frankfurter Stammwerk und an drei weiteren Standorten als Experiment begann, hat sich längst als erfolgreiches Geschäftsmodell in der Branche etabliert.

Die Dokumentation nimmt im Anlagenbau einen hohen Stellenwert ein. Denn schließlich ist sie per Gesetz vorgeschrieben und verschiedenen Regularien unterworfen. Das gilt besonders für die Chemie- und Pharmabranche, die eine Fülle von Auflagen zu erfüllen hat.

Einen aktuellen und detaillierten Überblick über die Landschaft der digitalen Chemikalien-Marktplätze bietet die dritte Version des Chembid Marketplaces Report. Rund 60 Online-Marktplätze, die auf den Handel mit Chemikalien spezialisiert sind, werden auf anschauliche und kompakte Art und Weise im frei verfügbaren Report gegenübergestellt. Der Report dient Branchenakteuren als Orientierung für ihre Recherche- und Beschaffungsprozesse.

A few generations back, the widely accepted concept of “clean” equated to “not dirty.”

Unsere Arbeitswelt und die Bedeutung der Arbeitszeit verändern sich rasant.

Wenn es um die Auswahl einer digitalen Zwillingslösung in der Prozessindustrie für die Planung und den Bau neuer Projekte geht, kann es schwierig sein, eine Lösung zu finden, die die Zusammenarbeit per Fernzugriff, die Überprüfung von Entwürfen und die Sicherstellung der Aktualität der Informationen zu jeder Zeit ermöglicht.

Welche zahlreichen Vorteile ein Einstieg in die Cloud bietet, ist mittlerweile in allen Branchen bekannt – und auch im Bereich Life Sciences wird das Thema Cloud immer relevanter.


Die digitale Transformation macht auch vor der Schließtechnik kritischer Infrastrukturen nicht halt.

Die Welt der Arbeit steht in diesem Jahr Kopf. Mit Eintritt des ersten Lockdowns im März 2020 wird das öffentliche Leben heruntergefahren, Geschäfte und Unternehmen schließen, Lieferketten brechen ab, und die Menschen bleiben überwiegend zu Hause.

Der Chembid Marketplaces Report liefert Antworten zu diesen und anderen Fragen rund um digitale B2B-Marktplätze aus aller Welt.

Das VAA Magazin ist die Zeitschrift für Führungskräfte in der Chemie und den angrenzenden Branchen.

Ohne Produkte, die direkt oder indirekt auf Chemikalien basieren, wäre das Leben, wie wir es kennen, nicht nachhaltig. Verschiedenen Quellen zufolge werden mehr als 95% der Produkte um uns herum entweder von der chemischen Industrie hergestellt oder beinhalten bei ihrer Herstellung mindestens einen chemischen Prozessschritt.
Multiparameter Messverfahren werden durch neue UV-Lasergeräte (349 nm und 360 nm) immer smarter - integrierte Lichtquellenmodule vereinfachen und beschleunigen die Entwicklung neuer Geräte.

In diesem Whitepaper geht es um digitale Anlagen-Zwillinge, die eine eine physisch vorhandene Anlage digital abbilden und 1D-, 2D- und 3D-Daten in einer einzigen visuellen Darstellung einer Anlage koordinieren.

Die wirksamste Form der menschlichen Kommunikation ist das persönliche Gespräch. Bis zum Auftreten der COVID-19-Pandemie nahmen die meisten Menschen diese Form der Kommunikation als selbstverständlich hin.

Kunststoffe haben dazu beigetragen, die moderne Welt aufzubauen. Sie sind unerlässlich, um eine nachhaltigere Gesellschaft zu schaffen und sicherzustellen, dass sich zukünftige Technologien schnell und kostengünstig entwickeln.

Ganz gleich ob Chemie und Pharma, Papierindustrie, Nahrungsmittel-, Werkstoff- oder Automotive-Industrie. Alle Industriebranchen stehen gleichermaßen vor der Herausforderung, ihre Produktion möglichst klimaneutral abzubilden und gleichzeitig wettbewerbsfähig zu bleiben.

Bedeutung der Logistik für die deutsche Wirtschaft

Digitale Technologien können Unternehmen helfen, nachhaltiger zu wirtschaften, Prozesse neu zu gestalten und neue zirkulär basierte Geschäftsmodelle zu entwickeln.

#Notfallschichtpläne - Für alle Betriebe, die durch die Coronakrise besonderen Herausforderungen ausgesetzt sind

Es tut sich einiges in der deutschen Chemie- und Life-Science-Start-up-Szene.

Dassault Systèmes bietet Unternehmen und Menschen virtuelle Universen, um sich nachhaltige Innovationen vorzustellen.

Der chembid Marketplaces Report umfasst mehr als 50 Marktplätze, auf denen Chemikalien gehandelt werden.

Kennt Ihr Unternehmen die Mindestschwellenwert für den digitalen Reifegrad von Ressourcen, Systemen, Organisation und Kultur, auf dessen Grundlage digitale Aktivitäten konzipiert werden können?

Zusammenfassungen der Vorträge und sechs Workshops